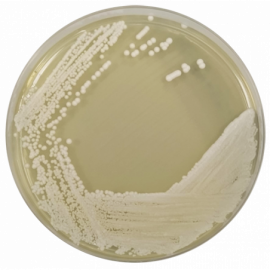

Yeast Extract Agar (YEA) ISO
Principles and uses
Yeast Extract Agar is a medium rich in nutrients that permits the recovery of a wide spectrum of bacteria, yeasts and molds. This medium is recommended by ISO 6222 for the plate count of microorganisms in all types of water, including for human consumption.
Tryptone provides nitrogen, vitamins, minerals and amino acids essential for growth. Yeast extract is the water-soluble portion of hydrolyzed yeast and is a source of vitamins, particularly of the B-group. Bacteriological agar is the solidifying agent.
The norm ISO 6222 recommend this medium for the enumeration of culturable microorganisms in potable water at 36 ºC and 22 ºC.
Preparation
Suspend 24 grams of the medium in one liter of distilled water. Mix well and dissolve by heating with frequent agitation. Boil for one minute until complete dissolution. Sterilize in autoclave at 121ºC for 15 minutes. Cool to 45±1 ºC, mix well and dispense into plates.